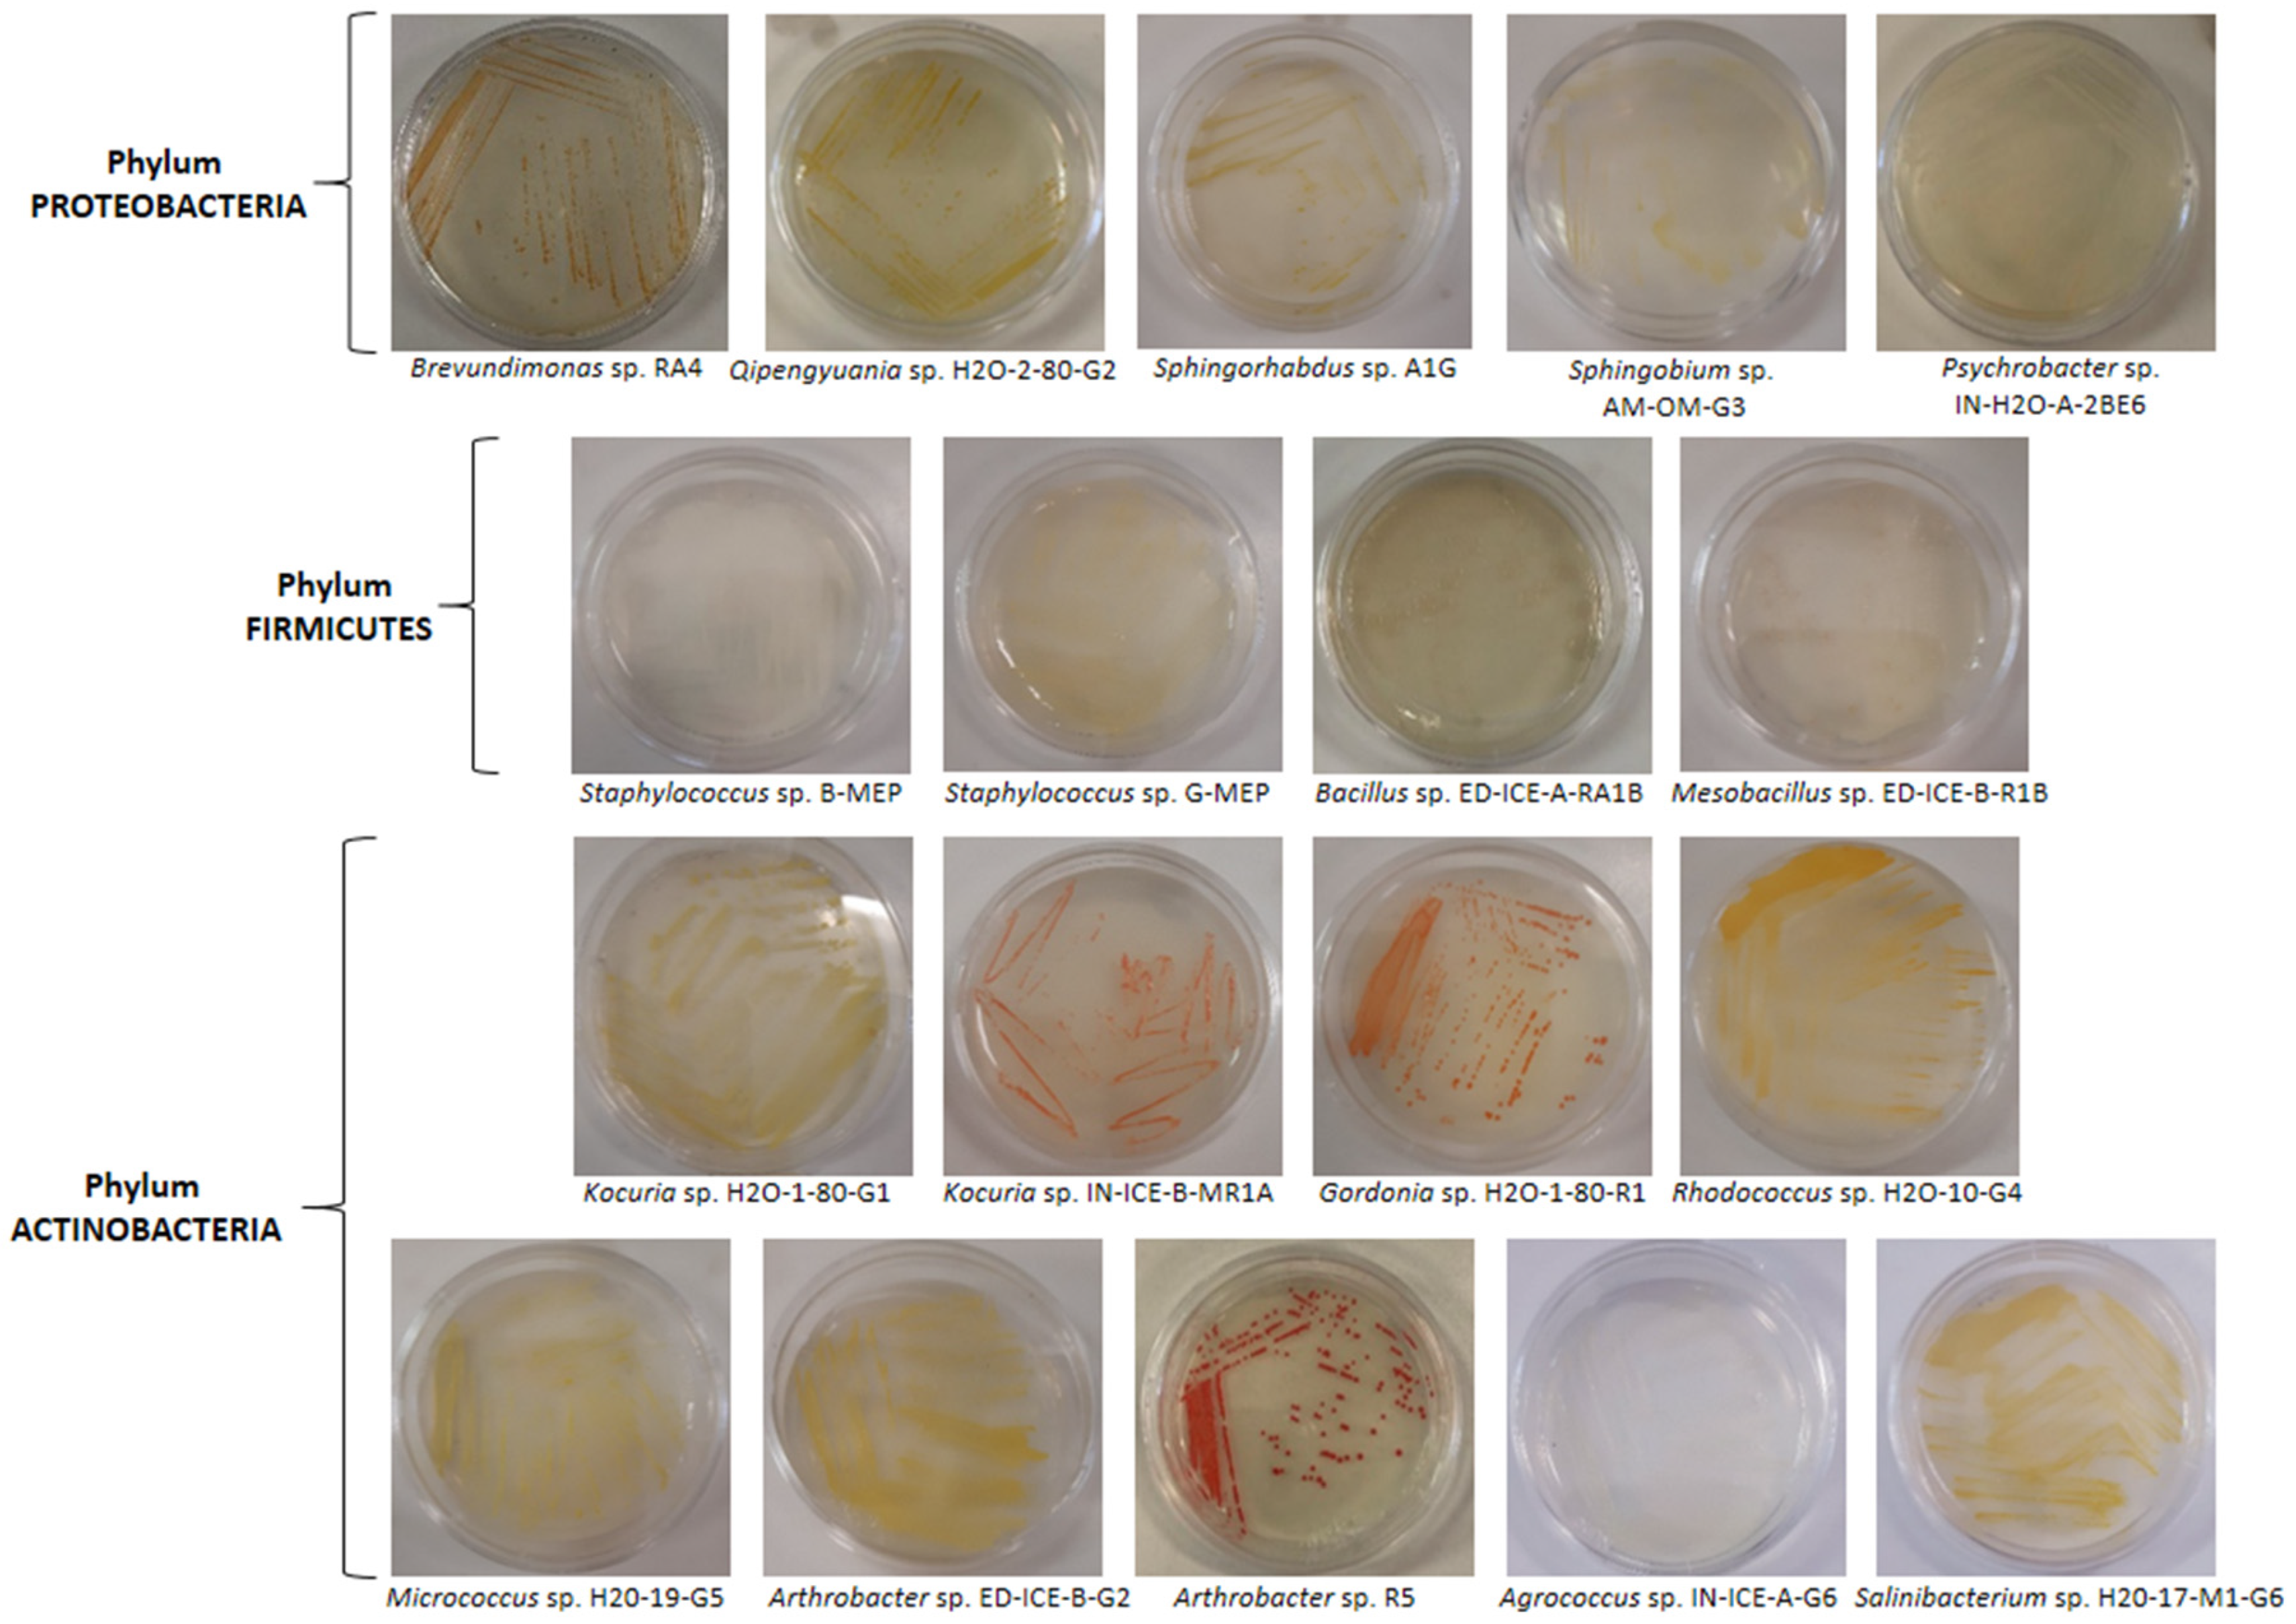
Jmse 11 00968 g002

Biodiversity of UV-Resistant Bacteria in Antarctic Aquatic Environments
Abstract
1. Introduction
2. Materials and Methods
2.1. Sampling
2.2. Media
2.3. Isolation and Selection of UV-Resistant Bacteria by UV-C Assay
2.4. PCR Amplification of 16S rRNA Gene of UV-Resistant Bacteria
2.5. Identification and Phylogenetic Analysis
3. Results ad Discussion
3.1. Sampling
3.2. Isolation and Identification of UV-Resistant Bacteria by UV-C Assay
| Strain | Pigmentation | Sample Source- Collection Site | Identification by 16S rRNA | UV-C Resistance (min) | Accession Number (AN) | Next Relative by GenBank Alignment (AN, Organism) | Sequence Homology (%) |
|---|---|---|---|---|---|---|---|
| Phylum PROTEOBACTERIA | |||||||
| Class Alphaproteobacteria (Gram negative) | |||||||
| RA4 | Reddish orange | Lake sediments—Edmonson Point (site 12) | Brevundimonas sp. | 6 | OQ540805 | EF093132.1, Brevundimonas sp. VTT E-052914 | 99.93 |
| ED-ICE-A-RA1 | Reddish orange | Sea ice—Edmonson Point (site 10) | Brevundimonas sp. | 3 | OQ540806 | EF093132.1, Brevundimonas sp. VTT E-052914 | 99.79 |
| IN-H2O-B-RA3 | Reddish orange | Sea water—Inexpressible Island (site 8) | Brevundimonas sp. | 3 | OQ540807 | AJ244710.1, Brevundimonas sp. V4.BP.05 | 100 |
| H2O-2-80-G2 | Brilliant yellow | Sea water/ice—Tethys Bay (site 1) | Qipengyuania sp. | 3 | OQ540808 | MZ749497.1, Qipengyuania aerophila GH25 | 100 |
| G5G | Yellow | Lake sediments—Edmonson Point (site 12) | Sphingorhabdus sp. | 6 | OQ540809 | MN255826.1, Sphingorhabdus soli D-2Q-5-6 | 100 |
| A1G | Yellow | Lake sediments—Edmonson Point (site 12) | Sphingorhabdus sp. | 6 | OQ540810 | MN255826.1, Sphingorhabdus soli D-2Q-5-6 | 100 |
| AM-0m-G3 1 | Pale yellow | Sea ice—Tethys Bay (site 3) | Sphingobium sp. | 3 | OQ540811 | CP016456.1, Sphingobium sp. RAC03 | 100 |
| Class Gammaproteobacteria (Gram negative) | |||||||
| IN-H2O-A-2BE6 | Creamy | Sea water—Inexpressible Island (site 7) | Psychrobacter sp. | 2 | OQ540812 | EU196303.1, Psychrobacter sp. NP52 | 99.64 |
| IN-ICE-A-A1B | Beige | Sea ice—Inexpressible Island (site 7) | Psychrobacter sp. | 2 | OQ540813 | CP012533.1, Psychrobacter sp. P11G5 | 99.87 |
| H2O-1-80-BE1 | Beige | Sea water—Edmonson Point (site 9) | Psychrobacter sp. | 3 | OQ540814 | ON209525.1, Psychrobacter okhotskensis PCRB17b | 99.86 |
| IN-ICE-A-A1G | Creamy | Sea ice—Inexpressible Island (site 7) | Psychrobacter sp. | 1 | OQ540815 | FR750957.1, Psychrobacter nivimaris CMS161 | 99.66 |
| Gly6-2-BE4 | Beige | Sea water—Tethys Bay (site 2) | Psychrobacter sp. | 3 | OQ540816 | KU579272.1, Psychrobacter nivimaris OUCMDZ4219 | 99.93 |
| Gly9-1-BE7 | Beige | Sea water—Road Bay (site 4) | Psychrobacter sp. | 1 | OQ540817 | CP106752.1, Psychrobacter sp. SC65A.3 | 100 |
| Phylum FIRMICUTES | |||||||
| Class Bacilli (Gram positive) | |||||||
| B-MEP | White | Sea water—Edmonson Point (site 9) | Staphylococcus sp. | 2 | OQ540818 | CP054831.1, Staphylococcus saprophyticus UTI-045 | 99.93 |
| G-MEP | Pale Yellow | Sea water—Edmonson Point (site 9) | Staphylococcus sp. | 2 | OQ540819 | CP054831.1, Staphylococcus saprophyticus UTI-045 | 99.93 |
| H2O-2-80-R3W | White | Sea water/ice—Tethys Bay (site 1) | Staphylococcus sp. | 1 | OQ540820 | MN826459.1, Staphylococcus saprophyticus TA1 | 100 |
| ED-ICE-B-R1B | Translucent white | Sea ice—Edmonson Point (site 11) | Mesobacillus sp. | 1 | OQ540821 | KY202702.1, Mesobacillus subterraneus A9 | 99.86 |
| ED-ICE-A-RA1B | Translucent white | Sea ice—Edmonson Point (site 10) | Bacillus sp. | 3 | OQ540822 | MT332156.1, Bacillus cereus DBA1.1 | 100 |
| Phylum ACTINOBACTERIA | |||||||
| Class Actinobacteria (Gram positive) | |||||||
| H2O-1-80-G1 | Brilliant yellow | Sea water—Edmonson Point (site 9) | Kocuria sp. | 3 | OQ540823 | AM237350.1, Kocuria carniphila OS-32.d1 | 99.93 |
| IN-H2O-A-BE6R | Red coral | Sea water—Inexpressible Island (site 7) | Kocuria sp. | 1 | OQ540824 | AM418390.1, Kocuria sp. 29Y1zhy | 99.93 |
| IN-ICE-B-MR1A | Red coral | Sea ice—Inexpressible Island (site 8) | Kocuria sp. | 1 | OQ540825 | CP035103.1, Kocuria rosea ATCC 186 | 99.93 |
| H2O-1-80-R1 | Brilliant orange | Sea water—Edmonson Point (site 9) | Gordonia sp. | 1 | OQ540826 | CP049836.1, Gordonia terrae RL-JC02 | 99.86 |
| H2O-2-80-R4 | Brilliant orange | Sea water/ice—Tethys Bay (site1) | Gordonia sp. | 1 | OQ540827 | CP049836.1, Gordonia terrae RL-JC02 | 100 |
| H2O-10-G4 | Yellowish orange | Sea water—Tethys Bay (site 2) | Rhodococcus sp. | 1 | OQ540828 | JX428873.1, Rhodococcus sp. ZS333 | 99.80 |
| H2O-19-G5 | Brilliant yellow | Sea water—Inexpressible Island (site 6) | Micrococcus sp. | 3 | OQ540829 | CP097650.1, Micrococcus yunnanensis TT9 | 99.86 |
| ED-ICE-B-R1G | Brilliant yellow | Sea ice—Edmonson Point (site 11) | Micrococcus sp. | 2 | OQ540830 | CP043842.1, Micrococcus luteus NCCP 16831 | 99.79 |
| ED-ICE-B-G2 | Brilliant yellow | Sea ice-Edmonson Point (site 11) | Arthrobacter sp. | 2 | OQ540831 | KR085775.1, Arthrobacter flavus IHBB 9551 | 100 |
| ED-ICE-B-R1 | Brilliant red | Sea ice—Edmonson Point (site 11) | Arthrobacter sp. | 1 | OQ540832 | JX949321.2, Arthrobacter cheniae | 99.73 |
| R5 | Brilliant red | Lake sediments—Edmonson Point (site 12) | Arthrobacter sp. | 6 | OQ540833 | KU921543.1, Arthrobacter agilis IHBB 9979 | 99.66 |
| IN-ICE-A-G6 1 | Creamy | Sea ice—Inexpressible Island (site 7) | Agrococcus sp. | 2 | OQ540834 | MW580037.1, Agrococcus sp. AHE_PA_072 | 99.72 |
| H2O-17-M1-G6 | Brilliant yellow | Sea ice—Inexpressible Island (site 5) | Salinibacterium sp. | 2 | OQ540835 | MK140978.1, Salinibacterium sp. s4a41-10 | 99.86 |
3.3. Diversity of UV-Resistant Antarctic Aquatic Bacteria and Phylogenetic Analysis
3.3.1. Actinobacteria
3.3.2. Proteobacteria
3.3.3. Firmicutes
4. Conclusions
Author Contributions
Funding
Institutional Review Board Statement
Informed Consent Statement
Data Availability Statement
Acknowledgments
Conflicts of Interest
References
- Santos, A.L.; Gomes, N.C.; Henriques, I.; Almeida, A.; Correia, A.; Cunha, Â. Contribution of reactive oxygen species to UV-B-induced damage in bacteria. J. Photochem. Photobiol. B Biol. 2012, 117, 40–46. [Google Scholar] [CrossRef] [PubMed]
- Zhao, X.; Drlica, K. Reactive oxygen species and the bacterial response to lethal stress. Curr. Opin. Microbiol. 2014, 21, 1–6. [Google Scholar] [CrossRef] [PubMed]
- Núñez-Pons, L.; Avila, C.; Romano, G.; Verde, C.; Giordano, D. UV-protective compounds in marine organisms from the Southern Ocean. Mar. Drugs 2018, 16, 336. [Google Scholar] [CrossRef] [PubMed]
- Blunt, J.W.; Carroll, A.R.; Copp, B.R.; Davis, R.A.; Keyzers, R.A.; Prinsep, M.R. Marine natural products. Nat. Prod. Rep. 2018, 35, 8–53. [Google Scholar] [CrossRef]
- Häder, D.-P.; Williamson, C.E.; Wängberg, S.-Å.; Rautio, M.; Rose, K.C.; Gao, K.; Helbling, E.W.; Sinha, R.P.; Worrest, R. Effects of UV radiation on aquatic ecosystems and interactions with other environmental factors. Photochem. Photobiol. Sci. 2015, 14, 108–126. [Google Scholar] [CrossRef]
- Cordero, R.R.; Damiani, A.; Ferrer, J.; Jorquera, J.; Tobar, M.; Labbe, F.; Carrasco, J.; Laroze, D. UV irradiance and albedo at Union Glacier Camp (Antarctica): A case study. PLoS ONE 2014, 9, e90705. [Google Scholar] [CrossRef]
- Tedetti, M.; Sempéré, R. Penetration of ultraviolet radiation in the marine environment. A review. Photochem. Photobiol. 2006, 82, 389–397. [Google Scholar] [CrossRef]
- Correa-Llantén, D.N.; Amenábar, M.J.; Blamey, J.M. Antioxidant capacity of novel pigments from an Antarctic bacterium. J. Microbiol. 2012, 50, 374–379. [Google Scholar] [CrossRef]
- Martín-Cerezo, M.L.; García-López, E.; Cid, C. Isolation and identification of a red pigment from the antarctic bacterium Shewanella; frigidimarina. Protein Pept. Lett. 2015, 22, 1076–1082. [Google Scholar] [CrossRef]
- Liao, L.; Su, S.; Zhao, B.; Fan, C.; Zhang, J.; Li, H.; Chen, B. Biosynthetic potential of a novel Antarctic Actinobacterium Marisediminicola antarctica ZS314T revealed by genomic data mining and pigment characterization. Mar. Drugs 2019, 17, 388. [Google Scholar] [CrossRef]
- Silva, T.R.; Canela-Garayoa, R.; Eras, J.; Rodrigues, M.V.; Dos Santos, F.N.; Eberlin, M.N.; Neri-Numa, I.A.; Pastore, G.M.; Tavares, R.S.; Debonsi, H.M. Pigments in an iridescent bacterium, Cellulophaga fucicola, isolated from Antarctica. Antonie Van Leeuwenhoek 2019, 112, 479–490. [Google Scholar] [CrossRef] [PubMed]
- Núñez-Pons, L.; Shilling, A.; Verde, C.; Baker, B.J.; Giordano, D. Marine terpenoids from polar latitudes and their potential applications in biotechnology. Mar. Drugs 2020, 18, 401. [Google Scholar] [CrossRef] [PubMed]
- Silva, T.R.e.; Silva, L.C.F.; de Queiroz, A.C.; Alexandre Moreira, M.S.; de Carvalho Fraga, C.A.; de Menezes, G.C.A.; Rosa, L.H.; Bicas, J.; de Oliveira, V.M.; Duarte, A.W.F. Pigments from Antarctic bacteria and their biotechnological applications. Crit. Rev. Biotechnol. 2021, 41, 809–826. [Google Scholar] [CrossRef] [PubMed]
- Giordano, D.; Coppola, D.; Russo, R.; Tinajero-Trejo, M.; di Prisco, G.; Lauro, F.; Ascenzi, P.; Verde, C. The globins of cold-adapted Pseudoalteromonas haloplanktis TAC125: From the structure to the physiological functions. Adv. Microb. Physiol. 2013, 63, 329–389. [Google Scholar] [PubMed]
- Chattopadhyay, M.; Raghu, G.; Sharma, Y.; Biju, A.; Rajasekharan, M.; Shivaji, S. Increase in oxidative stress at low temperature in an Antarctic bacterium. Curr. Microbiol. 2011, 62, 544–546. [Google Scholar] [CrossRef] [PubMed]
- He, Y.; Qu, C.; Zhang, L.; Miao, J. DNA photolyase from Antarctic marine bacterium Rhodococcus sp. NJ-530 can repair DNA damage caused by ultraviolet. 3 Biotech 2021, 11, 102. [Google Scholar] [CrossRef]
- Marizcurrena, J.J.; Martínez-López, W.; Ma, H.; Lamparter, T.; Castro-Sowinski, S. A highly efficient and cost-effective recombinant production of a bacterial photolyase from the Antarctic isolate Hymenobacter sp. UV11. Extremophiles 2019, 23, 49–57. [Google Scholar] [CrossRef]
- Marizcurrena, J.J.; Morel, M.A.; Braña, V.; Morales, D.; Martinez-López, W.; Castro-Sowinski, S. Searching for novel photolyases in UVC-resistant Antarctic bacteria. Extremophiles 2017, 21, 409–418. [Google Scholar] [CrossRef]
- Marizcurrena, J.J.; Herrera, L.M.; Costábile, A.; Morales, D.; Villadóniga, C.; Eizmendi, A.; Davyt, D.; Castro-Sowinski, S. Validating biochemical features at the genome level in the Antarctic bacterium Hymenobacter sp. strain UV11. FEMS Microbiol. Lett. 2019, 366, fnz177. [Google Scholar] [CrossRef]
- Marizcurrena, J.J.; Acosta, S.; Canclini, L.; Hernández, P.; Vallés, D.; Lamparter, T.; Castro-Sowinski, S. A natural occurring bifunctional CPD/(6-4)-photolyase from the Antarctic bacterium Sphingomonas sp. UV9. Appl. Microbiol. Biotechnol. 2020, 104, 7037–7050. [Google Scholar] [CrossRef]
- Coppola, D.; Verde, C.; Giordano, D. Isolation of UV-Resistant Marine Bacteria by UV-C Assays. In Marine Genomics; Springer: New York, NY, USA, 2022; Volume 2498, pp. 293–305. [Google Scholar]
- Órdenes-Aenishanslins, N.; Anziani-Ostuni, G.; Vargas-Reyes, M.; Alarcón, J.; Tello, A.; Pérez-Donoso, J. Pigments from UV-resistant Antarctic bacteria as photosensitizers in dye sensitized solar cells. J. Photochem. Photobiol. B Biol. 2016, 162, 707–714. [Google Scholar] [CrossRef] [PubMed]
- Weisburg, W.G.; Barns, S.M.; Pelletier, D.A.; Lane, D.J. 16S ribosomal DNA amplification for phylogenetic study. J. Bacteriol. 1991, 173, 697–703. [Google Scholar] [CrossRef] [PubMed]
- Youssef, N.H.; Couger, M.B.; McCully, A.L.; Criado, A.E.; Elshahed, M.S. Assessing the global phylum level diversity within the bacterial domain: A review. J. Adv. Res. 2015, 6, 269–282. [Google Scholar] [CrossRef] [PubMed]
- Tamura, K.; Stecher, G.; Peterson, D.; Filipski, A.; Kumar, S. MEGA6: Molecular evolutionary genetics analysis version 6.0. Mol. Biol. Evol. 2013, 30, 2725–2729. [Google Scholar] [CrossRef] [PubMed]
- Thompson, J.D.; Higgins, D.G.; Gibson, T.J. CLUSTAL W: Improving the sensitivity of progressive multiple sequence alignment through sequence weighting, position-specific gap penalties and weight matrix choice. Nucleic Acids Res. 1994, 22, 4673–4680. [Google Scholar] [CrossRef] [PubMed]
- Jukes, T.H.; Cantor, C.R. Evolution of protein molecules. Mamm. Protein Metab. 1969, 3, 21–132. [Google Scholar]
- Giovannetti, R.; Alibabaei, L.; Zannotti, M.; Ferraro, S.; Petetta, L. HPLC-DAD-ESI/MS identification of light harvesting and light screening pigments in the lake sediments at edmonson point. Sci. World J. 2013, 2013, 741906. [Google Scholar] [CrossRef]
- Laybourn-Parry, J. Survival mechanisms in Antarctic lakes. Philos. Trans. R. Soc. Lond. Ser. B Biol. Sci. 2002, 357, 863–869. [Google Scholar] [CrossRef]
- Michaud, L.; Caruso, C.; Mangano, S.; Interdonato, F.; Bruni, V.; Lo Giudice, A. Predominance of Flavobacterium, Pseudomonas, and Polaromonas within the prokaryotic community of freshwater shallow lakes in the northern Victoria Land, East Antarctica. FEMS Microbiol. Ecol. 2012, 82, 391–404. [Google Scholar] [CrossRef]
- Archer, S.D.; McDonald, I.R.; Herbold, C.W.; Lee, C.K.; Cary, C.S. Benthic microbial communities of coastal terrestrial and ice shelf Antarctic meltwater ponds. Front. Microbiol. 2015, 6, 485. [Google Scholar] [CrossRef]
- Antony, R.; Sanyal, A.; Kapse, N.; Dhakephalkar, P.K.; Thamban, M.; Nair, S. Microbial communities associated with Antarctic snow pack and their biogeochemical implications. Microbiol. Res. 2016, 192, 192–202. [Google Scholar] [CrossRef] [PubMed]
- Núñez-Montero, K.; Barrientos, L. Advances in Antarctic research for antimicrobial discovery: A comprehensive narrative review of bacteria from Antarctic environments as potential sources of novel antibiotic compounds against human pathogens and microorganisms of industrial importance. Antibiotics 2018, 7, 90. [Google Scholar] [CrossRef] [PubMed]
- Camacho, A. Planktonic microbial assemblages and the potential effects of metazooplankton predation on the food web of lakes from the maritime Antarctica and sub-Antarctic islands. Rev. Environ. Sci. Bio/Technol. 2006, 5, 167–185. [Google Scholar] [CrossRef]
- Baker, J.M.; Vander Schaaf, N.A.; Cunningham, A.M.; Hang, A.C.; Reeves, C.L.; Huffman, E.R.; Riester, C.J.; Madigan, M.T.; Sattley, W.M. Chemoorganotrophic bacteria from Lake Fryxell, Antarctica, including Pseudomonas strain LFY10, a cold-adapted, halotolerant bacterium useful in teaching labs. Front. Microbiol. 2019, 10, 156. [Google Scholar] [CrossRef]
- Kim, S.B.; Nedashkovskaya, O.I.; Mikhailov, V.V.; Han, S.K.; Kim, K.-O.; Rhee, M.-S.; Bae, K.S. Kocuria marina sp. nov. a novel actinobacterium isolated from marine sediment. Int. J. Syst. Evol. Microbiol. 2004, 54, 1617–1620. [Google Scholar] [CrossRef] [PubMed]
- Sutthiwong, N.; Fouillaud, M.; Valla, A.; Caro, Y.; Dufossé, L. Bacteria belonging to the extremely versatile genus Arthrobacter as novel source of natural pigments with extended hue range. Food Res. Int. 2014, 65, 156–162. [Google Scholar] [CrossRef]
- Fiedor, J.; Burda, K. Potential role of carotenoids as antioxidants in human health and disease. Nutrients 2014, 6, 466–488. [Google Scholar] [CrossRef]
- Maoka, T. Carotenoids as natural functional pigments. J. Nat. Med. 2020, 74, 1–16. [Google Scholar] [CrossRef]
- Dieser, M.; Greenwood, M.; Foreman, C.M. Carotenoid pigmentation in Antarctic heterotrophic bacteria as a strategy to withstand environmental stresses. Arct. Antarct. Alp. Res. 2010, 42, 396–405. [Google Scholar] [CrossRef]
- Fong, N.; Burgess, M.; Barrow, K.; Glenn, D. Carotenoid accumulation in the psychrotrophic bacterium Arthrobacter agilis in response to thermal and salt stress. Appl. Microbiol. Biotechnol. 2001, 56, 750–756. [Google Scholar] [CrossRef]
- Reis-Mansur, M.C.P.; Cardoso-Rurr, J.S.; Silva, J.V.; de Souza, G.R.; Cardoso, V.d.S.; Mansoldo, F.R.P.; Pinheiro, Y.; Schultz, J.; Lopez Balottin, L.B.; da Silva, A.J.R. Carotenoids from UV-resistant Antarctic Microbacterium sp. LEMMJ01. Sci. Rep. 2019, 9, 9554. [Google Scholar] [CrossRef] [PubMed]
- Ram, S.; Mitra, M.; Shah, F.; Tirkey, S.R.; Mishra, S. Bacteria as an alternate biofactory for carotenoid production: A review of its applications, opportunities and challenges. J. Funct. Foods 2020, 67, 103867. [Google Scholar] [CrossRef]
- Venil, C.K.; Dufossé, L.; Renuka Devi, P. Bacterial pigments: Sustainable compounds with market potential for pharma and food industry. Front. Sustain. Food Syst. 2020, 4, 100. [Google Scholar] [CrossRef]
- Lopes, F.C.; Ligabue-Braun, R. Agro-industrial residues: Eco-friendly and inexpensive substrates for microbial pigments production. Front. Sustain. Food Syst. 2021, 5, 589414. [Google Scholar] [CrossRef]
- Velmurugan, P.; Venil, C.K.; Veera Ravi, A.; Dufossé, L. Marine bacteria is the cell factory to produce bioactive pigments: A prospective pigment source in the ocean. Front. Sustain. Food Syst. 2020, 4, 589655. [Google Scholar] [CrossRef]
- Soliev, A.B.; Hosokawa, K.; Enomoto, K. Bioactive pigments from marine bacteria: Applications and physiological roles. Evid.-Based Complement. Altern. Med. Ecam 2011, 2011, 670349. [Google Scholar] [CrossRef]
- Galasso, C.; Corinaldesi, C.; Sansone, C. Carotenoids from marine organisms: Biological functions and industrial applications. Antioxidants 2017, 6, 96. [Google Scholar] [CrossRef]
- Nawaz, A.; Chaudhary, R.; Shah, Z.; Dufossé, L.; Fouillaud, M.; Mukhtar, H.; ul Haq, I. An overview on industrial and medical applications of bio-pigments synthesized by marine bacteria. Microorganisms 2020, 9, 11. [Google Scholar] [CrossRef]
- Koch, C.; Schumann, P.; Stackebrandt, E. Reclassification of Micrococcus agilis (Ali-Cohen 1889) to the genus Arthrobacter as Arthrobacter agilis comb. nov. and emendation of the genus Arthrobacter. Int. J. Syst. Evol. Microbiol. 1995, 45, 837–839. [Google Scholar] [CrossRef]
- Yang, L.-L.; Liu, H.-C.; Liu, Q.; Xin, Y.-H. Arthrobacter cheniae and Arthrobacter frigidicola sp. nov. isolated from a glacier. Int. J. Syst. Evol. Microbiol. 2021, 71, 005177. [Google Scholar] [CrossRef]
- Reddy, G.; Aggarwal, R.; Matsumoto, G.; Shivaji, S. Arthrobacter flavus sp. nov. a psychrophilic bacterium isolated from a pond in McMurdo Dry Valley, Antarctica. Int. J. Syst. Evol. Microbiol. 2000, 50, 1553–1561. [Google Scholar] [CrossRef] [PubMed]
- Wietz, M.; Månsson, M.; Bowman, J.S.; Blom, N.; Ng, Y.; Gram, L. Wide distribution of closely related, antibiotic-producing Arthrobacter strains throughout the Arctic Ocean. Appl. Environ. Microbiol. 2012, 78, 2039–2042. [Google Scholar] [CrossRef] [PubMed]
- Dsouza, M.; Taylor, M.W.; Turner, S.J.; Aislabie, J. Genomic and phenotypic insights into the ecology of Arthrobacter from Antarctic soils. BMC Genom. 2015, 16, 36. [Google Scholar] [CrossRef] [PubMed]
- Yadav, A.N.; Sachan, S.G.; Verma, P.; Saxena, A.K. Prospecting cold deserts of north western Himalayas for microbial diversity and plant growth promoting attributes. J. Biosci. Bioeng. 2015, 119, 683–693. [Google Scholar] [CrossRef] [PubMed]
- Mukhia, S.; Khatri, A.; Acharya, V.; Kumar, R. Comparative genomics and molecular adaptational analysis of Arthrobacter from Sikkim Himalaya provided insights into its survivability under multiple high-altitude stress. Genomics 2021, 113, 151–158. [Google Scholar] [CrossRef] [PubMed]
- Silva, T.R.; Tavares, R.S.; Canela-Garayoa, R.; Eras, J.; Rodrigues, M.V.; Neri-Numa, I.A.; Pastore, G.M.; Rosa, L.H.; Schultz, J.A.; Debonsi, H.M. Chemical characterization and biotechnological applicability of pigments isolated from Antarctic bacteria. Mar. Biotechnol. 2019, 21, 416–429. [Google Scholar] [CrossRef] [PubMed]
- Flegler, A.; Lipski, A. The C50 carotenoid bacterioruberin regulates membrane fluidity in pink-pigmented Arthrobacter species. Arch. Microbiol. 2022, 204, 70. [Google Scholar] [CrossRef] [PubMed]
- Vila, E.; Hornero-Méndez, D.; Azziz, G.; Lareo, C.; Saravia, V. Carotenoids from heterotrophic bacteria isolated from fildes peninsula, king george island, antarctica. Biotechnol. Rep. 2019, 21, e00306. [Google Scholar] [CrossRef]
- Yu, X.; Jiang, K.; Zhang, W.; Dong, S.; Wu, Y.; Zhang, G.; Wu, S.; Chen, T.; Liu, G. Purification, Identification, and Properties of a Novel Carotenoid Produced by Arthrobacter sp. QL17 Isolated from Mount Qomolangma. Antioxidants 2022, 11, 1493. [Google Scholar] [CrossRef]
- Afra, S.; Makhdoumi, A.; Matin, M.; Feizy, J. A novel red pigment from marine Arthrobacter sp. G20 with specific anticancer activity. J. Appl. Microbiol. 2017, 123, 1228–1236. [Google Scholar] [CrossRef]
- Romaniuk, K.; Golec, P.; Dziewit, L. Insight into the diversity and possible role of plasmids in the adaptation of psychrotolerant and metalotolerant Arthrobacter spp. to extreme Antarctic environments. Front. Microbiol. 2018, 9, 3144. [Google Scholar] [CrossRef]
- Tvrzova, L.; Schumann, P.; Sedláček, I.; Páčová, Z.; Spröer, C.; Verbarg, S.; Kroppenstedt, R.M. Reclassification of strain CCM 132, previously classified as Kocuria varians, as Kocuria carniphila sp. nov. Int. J. Syst. Evol. Microbiol. 2005, 55, 139–142. [Google Scholar] [CrossRef] [PubMed]
- Gholami, M.; Etemadifar, Z.; Bouzari, M. Isolation a new strain of Kocuria rosea capable of tolerating extreme conditions. J. Environ. Radioact. 2015, 144, 113–119. [Google Scholar] [CrossRef] [PubMed]
- Lee, J.Y.; Kim, S.H.; Jeong, H.S.; Oh, S.H.; Kim, H.R.; Kim, Y.H.; Lee, J.N.; Kook, J.-K.; Kho, W.-G.; Bae, I.K. Two cases of peritonitis caused by Kocuria marina in patients undergoing continuous ambulatory peritoneal dialysis. J. Clin. Microbiol. 2009, 47, 3376–3378. [Google Scholar] [CrossRef] [PubMed]
- Shirsalimian, M.S.; Sepahy, A.A.; Amoozegar, M.A.; Kalantar, S.M.; Dabbagh, R. Isolation of a mesophilic and halotolerant strain of Kocuriapolaris from Gandom Beryan area in the Lut Desert of Iran, moderately resistant to gamma radiation and desiccation. Biosci. Biotechnol. Res. Asia 2016, 13, 2343–2350. [Google Scholar] [CrossRef]
- Godini, E.; Asgarani, E.; Fooladi, J.; Ghashghaei, T. Optimization of catalase production by Kocuria sp. ASB107 using response surface methodology and molasses as the carbon source. J. Appl. Biotechnol. Rep. 2017, 4, 519–525. [Google Scholar]
- Timkina, E.; Drábová, L.; Palyzová, A.; Řezanka, T.; Maťátková, O.; Kolouchová, I. Kocuria Strains from Unique Radon Spring Water from Jachymov Spa. Fermentation 2022, 8, 35. [Google Scholar] [CrossRef]
- Samanta, A.K.; Chaudhuri, S.; Dutta, D. Antioxidant efficacy of carotenoid extract from bacterial strain Kocuria marina DAGII. Mater. Today Proc. 2016, 3, 3427–3433. [Google Scholar] [CrossRef]
- Kuo, V.; Shoemaker, W.; Muscarella, M.; Lennon, J. Whole-genome sequence of the soil bacterium Micrococcus sp. KBS0714. Genome Announc. 2017, 5, e00697-17. [Google Scholar] [CrossRef]
- Liu, H.; Xu, Y.; Ma, Y.; Zhou, P. Characterization of Micrococcus antarcticus sp. nov. a psychrophilic bacterium from Antarctica. Int. J. Syst. Evol. Microbiol. 2000, 50, 715–719. [Google Scholar] [CrossRef]
- Lennon, J.T.; Aanderud, Z.T.; Lehmkuhl, B.; Schoolmaster, D.R., Jr. Mapping the niche space of soil microorganisms using taxonomy and traits. Ecology 2012, 93, 1867–1879. [Google Scholar] [CrossRef] [PubMed]
- Prasad, S.; Manasa, P.; Buddhi, S.; Tirunagari, P.; Begum, Z.; Rajan, S.; Shivaji, S. Diversity and bioprospective potential (cold-active enzymes) of cultivable marine bacteria from the subarctic glacial fjord, Kongsfjorden. Curr. Microbiol. 2014, 68, 233–238. [Google Scholar] [CrossRef] [PubMed]
- Han, S.K.; Nedashkovskaya, O.I.; Mikhailov, V.V.; Kim, S.B.; Bae, K.S. Salinibacterium amurskyense gen. nov. sp. nov. a novel genus of the family Microbacteriaceae from the marine environment. Int. J. Syst. Evol. Microbiol. 2003, 53, 2061–2066. [Google Scholar] [CrossRef]
- Zhang, D.-C.; Liu, H.-C.; Xin, Y.-H.; Yu, Y.; Zhou, P.-J.; Zhou, Y.-G. Salinibacterium xinjiangense sp. nov. a psychrophilic bacterium isolated from the China No. 1 glacier. Int. J. Syst. Evol. Microbiol. 2008, 58, 2739–2742. [Google Scholar] [CrossRef] [PubMed]
- Shin, S.C.; Kim, S.J.; Ahn, D.H.; Lee, J.K.; Lee, H.; Lee, J.; Hong, S.G.; Lee, Y.M.; Park, H. Genome sequence of a Salinibacterium sp. isolated from Antarctic soil. J Bacteriol. 2012, 194, 2404. [Google Scholar] [CrossRef]
- Smirnova, M.; Miamin, U.; Kohler, A.; Valentovich, L.; Akhremchuk, A.; Sidarenka, A.; Dolgikh, A.; Shapaval, V. Isolation and characterization of fast-growing green snow bacteria from coastal East Antarctica. MicrobiologyOpen 2021, 10, e1152. [Google Scholar] [CrossRef] [PubMed]
- Millán-Aguiñaga, N.; Soldatou, S.; Brozio, S.; Munnoch, J.T.; Howe, J.; Hoskisson, P.A.; Duncan, K.R. Awakening ancient polar Actinobacteria: Diversity, evolution and specialized metabolite potential. Microbiology 2019, 165, 1169–1180. [Google Scholar] [CrossRef] [PubMed]
- White III, R.A.; Gavelis, G.; Soles, S.A.; Gosselin, E.; Slater, G.F.; Lim, D.S.; Leander, B.; Suttle, C.A. The Complete genome and physiological analysis of the microbialite-dwelling Agrococcus pavilionensis sp. nov; reveals genetic promiscuity and predicted adaptations to environmental stress. Front. Microbiol. 2018, 9, 2180. [Google Scholar] [CrossRef]
- Li, H.-R.; Yu, Y.; Luo, W.; Zeng, Y.-X. Marisediminicola antarctica gen. nov. sp. nov. an actinobacterium isolated from the Antarctic. Int. J. Syst. Evol. Microbiol. 2010, 60, 2535–2539. [Google Scholar] [CrossRef]
- Jani, K.; Kajale, S.; Shetye, M.; Palkar, S.; Sharma, A. Marisediminicola senii sp. nov. isolated from Queen Maud Land, Antarctica. Int. J. Syst. Evol. Microbiol. 2021, 71, 004641. [Google Scholar] [CrossRef]
- Donini, E.; Firrincieli, A.; Cappelletti, M. Systems biology and metabolic engineering of Rhodococcus for bioconversion and biosynthesis processes. Folia Microbiol. 2021, 66, 701–713. [Google Scholar] [CrossRef] [PubMed]
- Chen, Y.; Xie, B.; Yang, J.; Chen, J.; Sun, Z. Identification of microbial carotenoids and isoprenoid quinones from Rhodococcus sp. B7740 and its stability in the presence of iron in model gastric conditions. Food Chem. 2018, 240, 204–211. [Google Scholar] [CrossRef]
- Drzyzga, O. The strengths and weaknesses of Gordonia: A review of an emerging genus with increasing biotechnological potential. Crit. Rev. Microbiol. 2012, 38, 300–316. [Google Scholar] [CrossRef] [PubMed]
- de Miguel, T.; Sieiro, C.; Poza, M.; Villa, T.G. Isolation and taxonomic study of a new canthaxanthin-containing bacterium, Gordonia jacobaea MV-1 sp. nov. Int. Microbiol. 2000, 3, 107–111. [Google Scholar] [PubMed]
- Yoon, J.-H.; Yeo, S.-H.; Oh, T.-K.; Park, Y.-H. Psychrobacter alimentarius sp. nov., isolated from squid jeotgal, a traditional Korean fermented seafood. Int. J. Syst. Evol. Microbiol. 2005, 55, 171–176. [Google Scholar] [CrossRef] [PubMed]
- Wang, Y.; Hou, Y.; Wang, Q. Cloning, expression, characterization, and antioxidant protection of glutaredoxin3 from psychrophilic bacterium Psychrobacter sp. ANT206. Front. Microbiol. 2021, 12, 633362. [Google Scholar] [CrossRef] [PubMed]
- Dziewit, L.; Cegielski, A.; Romaniuk, K.; Uhrynowski, W.; Szych, A.; Niesiobedzki, P.; Zmuda-Baranowska, M.J.; Zdanowski, M.K.; Bartosik, D. Plasmid diversity in arctic strains of Psychrobacter spp. Extremophiles 2013, 17, 433–444. [Google Scholar] [CrossRef][Green Version]
- Ciok, A.; Dziewit, L. Exploring the genome of Arctic Psychrobacter sp. DAB_AL32B and construction of novel Psychrobacter-specific cloning vectors of an increased carrying capacity. Arch. Microbiol. 2019, 201, 559–569. [Google Scholar] [CrossRef]
- Fritz, I.; Strömpl, C.; Nikitin, D.I.; Lysenko, A.; Abraham, W.-R. Brevundimonas mediterranea sp. nov., a non-stalked species from the Mediterranean Sea. Int. J. Syst. Evol. Microbiol. 2005, 55, 479–486. [Google Scholar] [CrossRef]
- Tahon, G.; Willems, A. Isolation and characterization of aerobic anoxygenic phototrophs from exposed soils from the Sør Rondane Mountains, East Antarctica. Syst. Appl. Microbiol. 2017, 40, 357–369. [Google Scholar] [CrossRef]
- Antony, R.; Krishnan, K.; Laluraj, C.; Thamban, M.; Dhakephalkar, P.; Engineer, A.S.; Shivaji, S. Diversity and physiology of culturable bacteria associated with a coastal Antarctic ice core. Microbiol. Res. 2012, 167, 372–380. [Google Scholar] [CrossRef] [PubMed]
- Epova, E.Y.; Shevelev, A.B.; Akbayev, R.M.; Biryukova, Y.K.; Zylkova, M.V.; Bogdanova, E.S.; Guseva, M.A.; Tynio, Y.Y.; Egorov, V.V. Heterotrophic Microbiota from the Oligotrophic Waters of Lake Vostok, Antarctica. Int. J. Environ. Res. Public Health 2022, 19, 4025. [Google Scholar] [CrossRef] [PubMed]
- Asker, D.; Awad, T.S.; Beppu, T.; Ueda, K. Screening and profiling of natural ketocarotenoids from environmental aquatic bacterial isolates. Food Chem. 2018, 253, 247–254. [Google Scholar] [CrossRef] [PubMed]
- Qu, J.-H.; Fu, Y.-H.; Li, X.-D.; Li, H.-F.; Tian, H.-L. Brevundimonas lutea sp. nov., isolated from lake sediment. Int. J. Syst. Evol. Microbiol. 2019, 69, 1417–1422. [Google Scholar] [CrossRef] [PubMed]
- Liu, H.; Zhang, C.; Zhang, X.; Tan, K.; Zhang, H.; Cheng, D.; Ye, T.; Li, S.; Ma, H.; Zheng, H. A novel carotenoids-producing marine bacterium from noble scallop Chlamys nobilis and antioxidant activities of its carotenoid compositions. Food Chem. 2020, 320, 126629. [Google Scholar] [CrossRef] [PubMed]
- Xu, L.; Sun, C.; Fang, C.; Oren, A.; Xu, X.-W. Genomic-based taxonomic classification of the family Erythrobacteraceae. Int. J. Syst. Evol. Microbiol. 2020, 70, 4470. [Google Scholar] [CrossRef]
- Lee, S.D.; Kim, I.S. Aurantiacibacter rhizosphaerae sp. nov., isolated from a rhizosphere mudflat of a halophyte and proposal to reclassify Erythrobacter suaedae Lee et al. 2019. and Erythrobacter flavus Yoon et al. 2003 as Aurantiacibacter suaedae comb. nov. and Qipengyuania flava comb. nov., respectively. Int. J. Syst. Evol. Microbiol. 2020, 70, 6257–6265. [Google Scholar]
- Liu, Y.; Pei, T.; Deng, M.-R.; Zhu, H. Qipengyuania soli sp. nov., Isolated from Mangrove Soil. Curr. Microbiol. 2021, 78, 2806–2814. [Google Scholar] [CrossRef]
- Liu, Y.; Pei, T.; Du, J.; Yao, Q.; Deng, M.-R.; Zhu, H. Comparative Genomics Reveals Genetic Diversity and Metabolic Potentials of the Genus Qipengyuania and Suggests Fifteen Novel Species. Microbiol. Spectr. 2022, 10, e01264-21. [Google Scholar] [CrossRef]
- Tareen, S.; Risdian, C.; Müsken, M.; Wink, J. Qipengyuania pacifica sp. nov., a Novel Carotenoid-Producing Marine Bacterium of the Family Erythrobacteraceae, Isolated from Sponge (Demospongiae), and Antimicrobial Potential of Its Crude Extract. Diversity 2022, 14, 295. [Google Scholar] [CrossRef]
- Kikukawa, H.; Okaya, T.; Maoka, T.; Miyazaki, M.; Murofushi, K.; Kato, T.; Hirono-Hara, Y.; Katsumata, M.; Miyahara, S.; Hara, K.Y. Carotenoid nostoxanthin production by Sphingomonas sp. SG73 isolated from deep sea sediment. Mar. Drugs 2021, 19, 274. [Google Scholar] [CrossRef] [PubMed]
- Li, A.-Z.; Han, X.-B.; Zhang, M.-X.; Zhou, Y.; Chen, M.; Yao, Q.; Zhu, H.-H. Culture-dependent and-independent analyses reveal the diversity, structure, and assembly mechanism of benthic bacterial community in the Ross Sea, Antarctica. Front. Microbiol. 2019, 10, 2523. [Google Scholar] [CrossRef] [PubMed]
- Marois, C.; Girard, C.; Klanten, Y.; Vincent, W.F.; Culley, A.I.; Antoniades, D. Local habitat filtering shapes microbial community structure in four closely spaced lakes in the High Arctic. Front. Microbiol. 2022, 13, 779505. [Google Scholar] [CrossRef] [PubMed]
- Silva, S.G.; Lago-Lestón, A.; Costa, R.; Keller-Costa, T. Draft genome sequence of Sphingorhabdus sp. strain EL138, a metabolically versatile Alphaproteobacterium isolated from the gorgonian coral Eunicella labiata. Genome Announc. 2018, 6, e00142-18. [Google Scholar] [CrossRef]
- Baraniecki, C.; Aislabie, J.; Foght, J.M. Characterization of Sphingomonas sp. Ant 17, an aromatic hydrocarbon-degrading bacterium isolated from Antarctic soil. Microb. Ecol. 2002, 43, 44–54. [Google Scholar] [CrossRef]
- Gran-Scheuch, A.; Fuentes, E.; Bravo, D.M.; Jiménez, J.C.; Pérez-Donoso, J.M. Isolation and Characterization of Phenanthrene Degrading Bacteria from Diesel Fuel-Contaminated Antarctic Soils. Front. Microbiol. 2017, 8, 1634. [Google Scholar] [CrossRef]
- Liu, X.; Gai, Z.; Tao, F.; Tang, H.; Xu, P. Carotenoids play a positive role in the degradation of heterocycles by Sphingobium yanoikuyae. PLoS ONE 2012, 7, e39522. [Google Scholar] [CrossRef]
- Patel, S.; Gupta, R.S. A phylogenomic and comparative genomic framework for resolving the polyphyly of the genus Bacillus: Proposal for six new genera of Bacillus species, Peribacillus gen. nov., Cytobacillus gen. nov., Mesobacillus gen. nov., Neobacillus gen. nov., Metabacillus gen. nov. and Alkalihalobacillus gen. nov. Int. J. Syst. Evol. Microbiol. 2020, 70, 406–438. [Google Scholar]
- Gaupp, R.; Ledala, N.; Somerville, G.A. Staphylococcal response to oxidative stress. Front. Cell. Infect. Microbiol. 2012, 2, 33. [Google Scholar] [CrossRef]
- Schleifer, K.H.; Kloos, W.E. Isolation and characterization of Staphylococci from human skin I. Amended descriptions of Staphylococcus epidermidis and Staphylococcus saprophyticus and descriptions of three new species: Staphylococcus cohnii, Staphylococcus haemolyticus, and Staphylococcus xylosus. Int. J. Syst. Evol. Microbiol. 1975, 25, 50–61. [Google Scholar]
- Becker, K.; Von Eiff, C. Staphylococcus, Micrococcus, and other catalase-positive cocci. In Manual of Clinical Microbiology, 10th ed.; ASM Press: Washington, DC, USA, 2011; pp. 308–330. [Google Scholar]
- Pantůček, R.; Sedláček, I.; Indráková, A.; Vrbovská, V.; Mašlaňová, I.; Kovařovic, V.; Švec, P.; Králová, S.; Krištofová, L.; Kekláková, J. Staphylococcus edaphicus sp. nov., isolated in Antarctica, harbors the mecC gene and genomic islands with a suspected role in adaptation to extreme environments. Appl. Environ. Microbiol. 2018, 84, e01746-17. [Google Scholar] [CrossRef] [PubMed]
- Du, H.; Jiao, N.; Hu, Y.; Zeng, Y. Diversity and distribution of pigmented heterotrophic bacteria in marine environments. FEMS Microbiol. Ecol. 2006, 57, 92–105. [Google Scholar] [CrossRef] [PubMed]
- Chiquito-Contreras, R.G.; Murillo-Amador, B.; Carmona-Hernandez, S.; Chiquito-Contreras, C.J.; Hernandez-Montiel, L.G. Effect of marine bacteria and ulvan on the activity of antioxidant defense enzymes and the bio-protection of papaya fruit against Colletotrichum gloeosporioides. Antioxidants 2019, 8, 580. [Google Scholar] [CrossRef] [PubMed]
- Khalid, N.; Asgher, M.; Hussain, F.; Iqbal, J. Exopolysaccharides production from marine Bacillus strains and their antioxidant and bio-flocculant capacities. Arch. Microbiol. 2022, 204, 250. [Google Scholar] [CrossRef] [PubMed]
- Abdel-Wahab, B.A.; Abd El-Kareem, H.F.; Alzamami, A.; Fahmy, C.A.; Elesawy, B.H.; Mostafa Mahmoud, M.; Ghareeb, A.; El Askary, A.; Abo Nahas, H.H.; Attallah, N.G.M.; et al. Novel Exopolysaccharide from Marine Bacillus subtilis with Broad Potential Biological Activities: Insights into Antioxidant, Anti-Inflammatory, Cytotoxicity, and Anti-Alzheimer Activity. Metabolites 2022, 12, 715. [Google Scholar] [CrossRef] [PubMed]
- Liu, W.; Boudry, P.; Bohn, C.; Bouloc, P. Staphylococcus aureus pigmentation is not controlled by Hfq. BMC Res. Notes 2020, 13, 63. [Google Scholar] [CrossRef]
- Otani, Y.; Maoka, T.; Kawai-Noma, S.; Saito, K.; Umeno, D. A novel carotenoid biosynthetic route via oxidosqualene. Biochem. Biophys. Res. Commun. 2022, 599, 75–80. [Google Scholar] [CrossRef]

| Collection Site | Location | Samples | Expedition | Coordinates |
|---|---|---|---|---|
| Site 1 | Tethys Bay | Surface sea water/ice | XXXIII | S 74°42′03.8″ |
| E 164°02′32.5″ | ||||
| Site 2 | Tethys Bay | Surface sea water 1 | XXXIII | S 74°42′00.2″ |
| E 164°02′34.8″ | ||||
| Site 3 | Tethys Bay | Surface sea water/ice | XXXIV | S 74°41′13.98″ |
| E 164° 2′11.76″ | ||||
| Site 4 | Road Bay | Surface sea water 1 | XXXIII | S 74°41′47.2″ |
| E 164°07′16.1″ | ||||
| Site 5 | Inexpressible Island | Surface sea ice | XXXIII | S 74°53′46.7″ |
| E 164°44′26.3″ | ||||
| Site 6 | Inexpressible Island | Surface sea water | XXXIII | S 74°53′47.1″ |
| E 163°44′27.2″ | ||||
| Site 7 | Inexpressible Island | Surface sea water/ice | XXXIV | S 74°53′45.60″ |
| E 63°44′31.68″ | ||||
| Site 8 | Inexpressible Island | Surface sea water/ice | XXXIV | S 74°53′47.94″ |
| E 63°44′37.80″ | ||||
| Site 9 | Edmonson Point | Surface sea water | XXXIII | S 74°19′57.4″ |
| E 165°08′52.1″ | ||||
| Site 10 | Edmonson Point | Surface sea water/ice | XXXIV | S 74°19′24″ |
| E 166°07′12″ | ||||
| Site 11 | Edmonson Point | Surface sea water/ice | XXXIV | S 74°19′44″ |
| E 165°25′40″ | ||||
| Site 12 | Edmonson Point | Shallow lake sediments | XXIX | S 74°20′11.12″ |
| E 65°07′53.02″ |
Disclaimer/Publisher’s Note: The statements, opinions and data contained in all publications are solely those of the individual author(s) and contributor(s) and not of MDPI and/or the editor(s). MDPI and/or the editor(s) disclaim responsibility for any injury to people or property resulting from any ideas, methods, instructions or products referred to in the content. |
© 2023 by the authors. Licensee MDPI, Basel, Switzerland. This article is an open access article distributed under the terms and conditions of the Creative Commons Attribution (CC BY) license (https://creativecommons.org/licenses/by/4.0/).
Share and Cite
Coppola, D.; Lauritano, C.; Zazo, G.; Nuzzo, G.; Fontana, A.; Ianora, A.; Costantini, M.; Verde, C.; Giordano, D. Biodiversity of UV-Resistant Bacteria in Antarctic Aquatic Environments. J. Mar. Sci. Eng. 2023, 11, 968. https://doi.org/10.3390/jmse11050968
Coppola D, Lauritano C, Zazo G, Nuzzo G, Fontana A, Ianora A, Costantini M, Verde C, Giordano D. Biodiversity of UV-Resistant Bacteria in Antarctic Aquatic Environments. Journal of Marine Science and Engineering. 2023; 11(5):968. https://doi.org/10.3390/jmse11050968
Chicago/Turabian StyleCoppola, Daniela, Chiara Lauritano, Gianluca Zazo, Genoveffa Nuzzo, Angelo Fontana, Adrianna Ianora, Maria Costantini, Cinzia Verde, and Daniela Giordano. 2023. "Biodiversity of UV-Resistant Bacteria in Antarctic Aquatic Environments" Journal of Marine Science and Engineering 11, no. 5: 968. https://doi.org/10.3390/jmse11050968
APA StyleCoppola, D., Lauritano, C., Zazo, G., Nuzzo, G., Fontana, A., Ianora, A., Costantini, M., Verde, C., & Giordano, D. (2023). Biodiversity of UV-Resistant Bacteria in Antarctic Aquatic Environments. Journal of Marine Science and Engineering, 11(5), 968. https://doi.org/10.3390/jmse11050968

